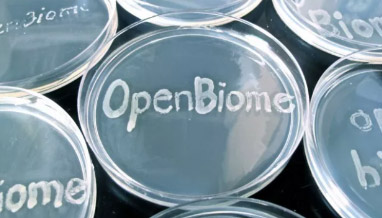

Microbiome
|
The Broad Institute and OpenBiome Microbiome Library (BIO-ML) now supplies a comprehensive collection of nearly 8,000 intestinal bacterial isolates, paired with nearly 4,000 genome sequences, to serve as an open access investigational resource. |
CRISPR

|
Feng Zhang's lab develops novel modular therapeutic platforms for treating human diseases. The lab is world renowned for their pioneering genome editing tools for functional genomics. As a useful resource for the research community, they host a CRISPR Google forum where scientists from institutions across the world can find answers to their questions about CRISPR usage in laboratory settings. Questions posted on the site are viewed and answered by members of the Zhang lab. Additional resources can be found on the Zhang lab website. |
